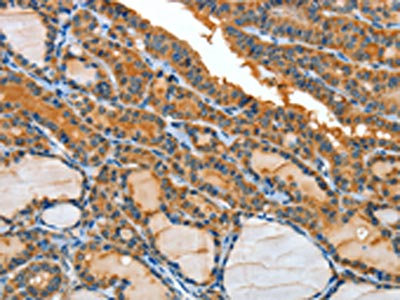

-
中文名稱:IL1R1兔多克隆抗體
-
貨號:CSB-PA727952
-
規格:¥1100
-
圖片:
-
The image on the left is immunohistochemistry of paraffin-embedded Human breast cancer tissue using CSB-PA727952(IL1R1 Antibody) at dilution 1/25, on the right is treated with fusion protein. (Original magnification: ×200)
-
The image on the left is immunohistochemistry of paraffin-embedded Human thyroid cancer tissue using CSB-PA727952(IL1R1 Antibody) at dilution 1/25, on the right is treated with fusion protein. (Original magnification: ×200)
-
-
其他:
產品詳情
-
Uniprot No.:
-
基因名:
-
別名:IL1R1; IL1R; IL1RA; IL1RT1; Interleukin-1 receptor type 1; IL-1R-1; IL-1RT-1; IL-1RT1; CD121 antigen-like family member A; Interleukin-1 receptor alpha; IL-1R-alpha; Interleukin-1 receptor type I; p80; CD antigen CD121a
-
宿主:Rabbit
-
反應種屬:Human,Mouse
-
免疫原:Fusion protein of Human IL1R1
-
免疫原種屬:Homo sapiens (Human)
-
標記方式:Non-conjugated
-
抗體亞型:IgG
-
純化方式:Antigen affinity purification
-
濃度:It differs from different batches. Please contact us to confirm it.
-
保存緩沖液:-20°C, pH7.4 PBS, 0.05% NaN3, 40% Glycerol
-
產品提供形式:Liquid
-
應用范圍:ELISA,IHC
-
推薦稀釋比:
Application Recommended Dilution ELISA 1:2000-1:5000 IHC 1:25-1:100 -
Protocols:
-
儲存條件:Upon receipt, store at -20°C or -80°C. Avoid repeated freeze.
-
貨期:Basically, we can dispatch the products out in 1-3 working days after receiving your orders. Delivery time maybe differs from different purchasing way or location, please kindly consult your local distributors for specific delivery time.
-
用途:For Research Use Only. Not for use in diagnostic or therapeutic procedures.
相關產品
靶點詳情
-
功能:Receptor for IL1A, IL1B and IL1RN. After binding to interleukin-1 associates with the coreceptor IL1RAP to form the high affinity interleukin-1 receptor complex which mediates interleukin-1-dependent activation of NF-kappa-B, MAPK and other pathways. Signaling involves the recruitment of adapter molecules such as TOLLIP, MYD88, and IRAK1 or IRAK2 via the respective TIR domains of the receptor/coreceptor subunits. Binds ligands with comparable affinity and binding of antagonist IL1RN prevents association with IL1RAP to form a signaling complex. Involved in IL1B-mediated costimulation of IFNG production from T-helper 1 (Th1) cells.
-
基因功能參考文獻:
- interleukin-1 receptor 1/MyD88 signalling has roles in the development and progression of pulmonary hypertension PMID: 27418552
- Study highlights the association of genetic polymorphisms of IL1R1 with knee osteoarthritis susceptibility in the Northwestern Chinese Han population. PMID: 27980229
- Serum ST2 is elevated in heart failure patients and correlated with disease severity. PMID: 28164491
- Since mumps virus SH coimmunoprecipitated with tumor necrosis factor receptor 1 (TNFR1), RIP1, and IRAK1, we hypothesize that SH exerts its NF-kappaB activation inhibitory function by interacting with TNFR1, interleukin-1 receptor type 1 (IL-1R1), and TLR3 complexes in the plasma membrane of infected cells. PMID: 28659487
- salt-inducible kinase inhibition decreases proinflammatory cytokines in human myeloid cells upon IL-1R stimulation. PMID: 26590148
- study confirmed that genetic variant in IL-1R1(rs3917267) has significant association with HBV infection and HBV breakthrough infection in children, which provides new clues for the study of pathogenesis of chronic HBV infection in children PMID: 28027994
- The results present identification of critical regions within the TIR domain of IL-1 receptor type in humans and mice. PMID: 26279140
- IL1R1 SNP rs949963 is associated with the susceptibility to asthma in children from Central China and may increase the serum expression of IL1R1. PMID: 26975823
- investigated the association between four inflammatory cytokines (CD121a, interleukin [IL]-1beta, IL-8, and IL-11) and coronary heart disease PMID: 26098632
- This study found that the mRNA expression of IL-1R1, TNFR1, and TNFR2 was significantly higher in schizophreina PMID: 25749018
- IL-1R1 expression appears to define a tissue regulatory T cell phenotype together with the expression of CD25, glucocorticoid-induced tumor necrosis factor receptor family-related gene and CTLA-4. PMID: 26076982
- TNF-alpha (-308) GG, IL-10 (-819) TT, IL-10 (-1082) GG and IL1R (+1970) CC genotypes are found to be predominant (p=0.01, p=0.02, p=0.0001 and p=0.001, respectively) in both tuberculoid as well as lepromatous leprosy patients. PMID: 25697140
- IL-1 receptor gene polymorphisms could be one of the factors influencing the expression of membrane-bound IL-1 receptors on immunocompetent cells. PMID: 24976267
- severe forms of pancreatitis are associated with increased levels of IL-6, IL-10 and IL-1ra PMID: 25240697
- SUMOylation is a novel mechanism in the regulation of beta-arrestin 2-mediated IL-1R/TRAF6 signaling PMID: 25425640
- genetic polymorphism is associated with atopic dermatitis in Iranian pediatric population PMID: 23253688
- Blood monocytes from renal cell carcinoma patients displayed a tumor-promoting transcriptional profile that supported functions like angiogenesis and invasion. Induction of this protumor phenotype required an interleukin-1 receptor (IL-1R)-dependent mechanism. PMID: 25453823
- the NLRP3 inflammasome/IL-1RI axis is dispensable for PM10-facilitated allergic sensitization. PMID: 24988285
- Thirty-eight single nucleotide polymorphisms (SNPs) were identified within genomic regions containing all exons and relevant exon-intron boundaries in IL1R1 and IL1R2 in japanese aggressive periodontitis. PMID: 24818754
- Only the IL1RN tandem repeats polymorphism may be associated with Hashimoto's thyroiditis susceptibility; TSHR and IL1RN polymorphisms may represent prognostic factors for predicting the severity of the disease. PMID: 24328419
- ). Findings provide evidence of subgroups of women with breast cancer who report distinct trajectories of attentional function and of a genetic association between subgroup membership and an IL1R1 promoter polymorphism. PMID: 24315345
- No significant differences are detected in the Fcgamma-RIIa and IL1-Ra polymorphisms compared to controls in a study to search for associations between antineutrophil cytoplasm antibody-associated vasculitis and IL1R1 polymorphisms. PMID: 24356554
- results demonstrate clear functional consequences of the rs917997 risk polymorphism; this polymorphism leads to a loss-of-function through decreased IL-18RAP, IL-18R1, and IL-1R1 protein expression, which impairs autocrine IL-18 and IL-1 signaling PMID: 24842757
- The frequency of the IL-1RN rs315952 CT genotype was significantly lower among patients with systemic lupus erythematosus compared with healthy controls PMID: 23722873
- Common IL-33 and IL1RL1 polymorphisms contribute to the risk of inflammatory bowel disease PMID: 23634226
- The IL1R1 promoter SNP rs2192752 may contribute to the location of papillary thyroid carcinoma (PTC), and the C allele of rs2192752 may be a risk factor for the development of PTC in both lobes. PMID: 22594576
- These results demonstrate that IL-1alpha and IL-1R1 signaling is essential for microabscess formation, neutrophil recruiting chemokine expression, and acanthosis in psoriasis-like skin inflammation induced by imiquimod. PMID: 23407395
- The internalization of IL1RI after IL-1 binding is not a mechanism of feedback inhibition but of critical importance for the IL-1-induced gene expression. PMID: 23022958
- Analysis of the data suggested that IL-1R1 expression in the neonatal period provides an additional level of Myd88-dependent signaling during this period of heighted susceptibility to infection. PMID: 22435759
- The IL-1R1 1498T>C polymorphism is associated with early-stage endometriosis in Korean women. PMID: 22509941
- a genetic link between rs1921622 IL1RL1 polymorphism and disease severity in RSV bronchiolitis PMID: 22574108
- This study demonistrated that Carriers of the minor allele for a single nucleotide polymorphism in interleukin (IL)1-receptor 1 (IL1R1) (rs2110726) were less likely to report breast pain prior to surgery PMID: 22515947
- the LCAP related changes in sIL-1RI and IL-1Ra might impact the clinical outcome during treatment with an LCAP filter in patients with inflammatory bowel disease PMID: 22267087
- No sufficient evidence was available to support any associations between IL1-Ra and IL6-147G/C polymorphisms and ischemic stroke. PMID: 22417897
- a role for TILRR in selective amplification of NF-kappaB responses through IL-1RI and suggest that the specificity is determined by changes in receptor conformation and adapter protein recruitment. PMID: 22262840
- The study presents the crystal structure of IL-1beta bound to its primary receptor IL-1RI and its receptor accessory protein IL-1RAcP. PMID: 22426547
- data demonstrated that IL-1R polymorphism is associated with susceptibility to ankylosing spondylitis PMID: 22285486
- regulates S100A8/A9-dependent keratinocyte resistance to bacterial invasion PMID: 22031183
- findings demonstrate that neutrophils express IL-1R1 and that IL-1R1 is induced following extravasation and exists in a mobile intracellular compartment PMID: 22385245
- Data sshow that variants in SFTPD, CD46 and IL1R1 are associated with IPD in both EA and AA. PMID: 21858107
- IL-1RI expression in regulatory T (Treg)cells identifies a subpopulation at an early stage of differentiation. PMID: 21998454
- This study found for the first time an epigallocatechin gallate-induced downregulation of the IL-1RI expression possibly being caused by NF-kappaB inhibition. PMID: 21787753
- IL-1RI expression was not altered in endometrioid carcinoma cells in comparison with endometrial cells, clear-cells, serous and mucinous ovarian cancer cells. PMID: 21083841
- Interleukin-1 receptor-mediated inflammation impairs the heat shock response of human mesothelial cells PMID: 21435443
- No association was found between recurrent spontaneous abortion and gene polymorphisms in the interleukin-1 receptor 1 gene. PMID: 20956022
- IL1RL1 polymorphisms are associated with serum IL1RL1-a, blood eosinophils, and asthma in childhood PMID: 21281963
- Serum levels of ECP, IL-5, -6, -8 and -10, G-CSF, MCP-1, IL-1 ra and IP-10 were significantly elevated in acute compared with stable childhhood asthma. PMID: 20523065
- This study indicated that statistically significant higher protein and mRNA levels of the il1r in frontal corte in bipolar disorder. PMID: 19488045
- findings that human Tregs preferentially express receptors for TNF and IL-1 suggest a potential function in sensing and dampening local inflammation PMID: 20066156
- An association between severe hand osteoarthritis and IL1R1 gene. PMID: 20353565
顯示更多
收起更多
-
亞細胞定位:Membrane; Single-pass type I membrane protein. Cell membrane. Secreted.
-
蛋白家族:Interleukin-1 receptor family
-
組織特異性:Expressed in T-helper cell subsets. Preferentially expressed in T-helper 1 (Th1) cells.
-
數據庫鏈接:
Most popular with customers
-
-
YWHAB Recombinant Monoclonal Antibody
Applications: ELISA, WB, IHC, IF, FC
Species Reactivity: Human, Mouse, Rat
-
Phospho-YAP1 (S127) Recombinant Monoclonal Antibody
Applications: ELISA, WB, IHC
Species Reactivity: Human
-
-
-
-
-